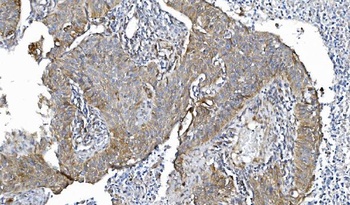
POR Antibody (monoclonal, 7F5)
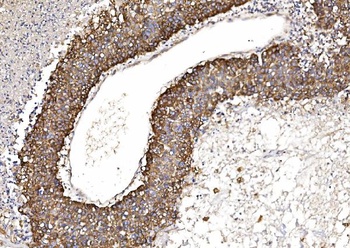
POR Antibody (monoclonal, 7F5)
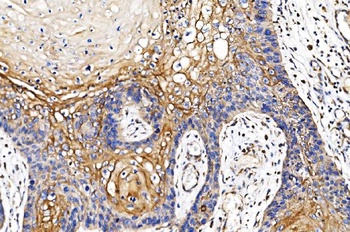
POR Antibody (monoclonal, 7F5)

POR Antibody (monoclonal, 7F5)
产品名:POR Antibody (monoclonal, 7F5)
货号:orb763206
产品中文名:POR Antibody (monoclonal, 7F5) 抗体
产品详情链接:
https://www.biorbyt.com/por-antibody-monoclonal-7f5-orb763206.html
Flow Cytometry analysis of SiHa cells using anti-POR antibody (orb763206). Overlay histogram showing SiHa cells stained with orb763206 (Blue line). The cells were blocked with 10% normal goat serum. And then incubated with mouse anti-POR Antibody (orb763206, 1 μg/1x10^6 cells) for 30 min at 20°C. DyLight®488 conjugated goat anti-mouse IgG (5-10 μg/1x10^6 cells) was used as secondary antibody for 30 minutes at 20°C. Isotype control antibody (Green line) was mouse IgG (1 μg/1x10^6) used under the same conditions. Unlabelled sample (Red line) was also used as a control.

IHC analysis of POR using anti-POR antibody (orb763206). POR was detected in a paraffin-embedded section of human placenta tissue. Heat mediated antigen retrieval was performed in EDTA buffer (pH 8.0, epitope retrieval solution). The tissue section was blocked with 10% goat serum. The tissue section was then incubated with 2 μg/ml mouse anti-POR Antibody (orb763206) overnight at 4°C. Biotinylated goat anti-mouse IgG was used as secondary antibody and incubated for 30 minutes at 37°C. The tissue section was developed using Strepavidin-Biotin-Complex (SABC) (Catalog # orb90443) with DAB as the chromogen.

IHC analysis of POR using anti-POR antibody (orb763206). POR was detected in a paraffin-embedded section of human lung cancer tissue. Heat mediated antigen retrieval was performed in EDTA buffer (pH 8.0, epitope retrieval solution). The tissue section was blocked with 10% goat serum. The tissue section was then incubated with 2 μg/ml mouse anti-POR Antibody (orb763206) overnight at 4°C. Biotinylated goat anti-mouse IgG was used as secondary antibody and incubated for 30 minutes at 37°C. The tissue section was developed using Strepavidin-Biotin-Complex (SABC) (Catalog # orb90443) with DAB as the chromogen.

IHC analysis of POR using anti-POR antibody (orb763206). POR was detected in a paraffin-embedded section of human liver cancer tissue. Heat mediated antigen retrieval was performed in EDTA buffer (pH 8.0, epitope retrieval solution). The tissue section was blocked with 10% goat serum. The tissue section was then incubated with 2 μg/ml mouse anti-POR Antibody (orb763206) overnight at 4°C. Biotinylated goat anti-mouse IgG was used as secondary antibody and incubated for 30 minutes at 37°C. The tissue section was developed using Strepavidin-Biotin-Complex (SABC) (Catalog # orb90443) with DAB as the chromogen.

IHC analysis of POR using anti-POR antibody (orb763206). POR was detected in a paraffin-embedded section of human esophageal squamous carcinoma tissue. Heat mediated antigen retrieval was performed in EDTA buffer (pH 8.0, epitope retrieval solution). The tissue section was blocked with 10% goat serum. The tissue section was then incubated with 2 μg/ml mouse anti-POR Antibody (orb763206) overnight at 4°C. Biotinylated goat anti-mouse IgG was used as secondary antibody and incubated for 30 minutes at 37°C. The tissue section was developed using Strepavidin-Biotin-Complex (SABC) (Catalog # orb90443) with DAB as the chromogen.

Western blot analysis of POR using anti-POR antibody (orb763206). Electrophoresis was performed on a 5-20% SDS-PAGE gel at 70V (Stacking gel)/90V (Resolving gel) for 2-3 hours. The sample well of each lane was loaded with 30 ug of sample under reducing conditions. Lane 1: human HepG2 whole cell lysates, Lane 2: human A549 whole cell lysates. After electrophoresis, proteins were transferred to a nitrocellulose membrane at 150 mA for 50-90 minutes. Blocked the membrane with 5% non-fat milk/TBS for 1.5 hour at RT. The membrane was incubated with mouse anti-POR antigen affinity purified monoclonal antibody (Catalog # orb763206) at 0.5 μg/mL overnight at 4°C, then washed with TBS-0.1%Tween 3 times with 5 minutes each and probed with a goat anti-mouse IgG-HRP secondary antibody at a dilution of 1:10000 for 1.5 hour at RT. The signal is developed using an Enhanced Chemiluminescent detection (ECL) kit (Catalog # orb90502) with Tanon 5200 system. A specific band was detected for POR at approximately 77 kDa. The expected band size for POR is at 77 kDa.
产品主推四大类:
一. 抗体(Antibody):79万种的一抗。可应用于Western blot,IP,IHC,IF,FACS,ELISA等实验。
二. 蛋白(Protien):13万种的高纯度蛋白。
三. elisa试剂盒(Elisa kit):可以提供超过9万种的ELISA试剂盒,包括人源,大鼠源,小鼠源等。
四. 小分子(Small Molecules):超过12万种的生物活性小分子,主要包括:拮抗剂、抑制剂、抗生素、天然产物。
所有Biorbyt品牌的抗体,蛋白,Elisa试剂盒,小分子等产品,国际航空低温运输,货期短,多数产品货期在1~2周,快捷便利。
我们为研究者们提供免费的、专业的、售前售中售后服务,为您的实验保驾护航。
更多详情请联系我们:027-87663101、15827569716。
风险提示:丁香通仅作为第三方平台,为商家信息发布提供平台空间。用户咨询产品时请注意保护个人信息及财产安全,合理判断,谨慎选购商品,商家和用户对交易行为负责。对于医疗器械类产品,请先查证核实企业经营资质和医疗器械产品注册证情况。

技术资料
技术资料









